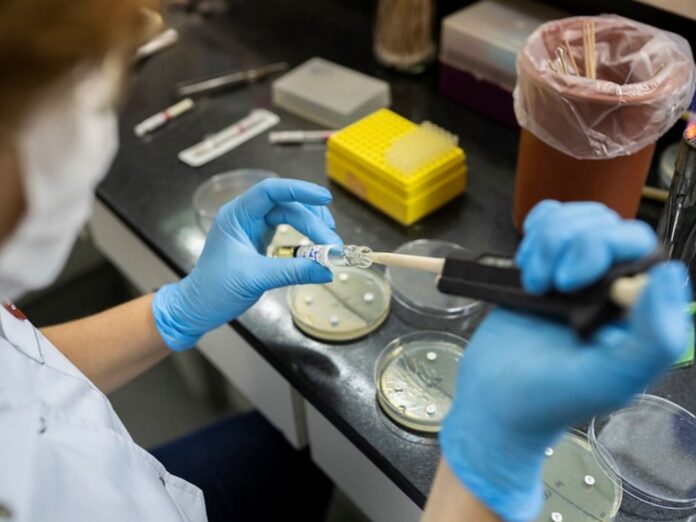

Alerta Sanitaria: Confirmados Tres Casos de Influenza A (H3N2) en Argentina
La detección de tres casos de influenza A (H3N2) en Argentina genera preocupación, pero los pacientes se recuperan sin complicaciones. El Instituto Malbrán brinda detalles sobre este importante hallazgo.
Este viernes, el Instituto Malbrán informó sobre la identificación de tres casos de influenza A (H3N2) correspondientes al subclado K en el país. El anuncio se realizó en el marco de una vigilancia activa sobre infecciones respiratorias agudas.
Detalles de los Casos Reportados
Los afectados incluyen a dos adolescentes en la provincia de Santa Cruz, quienes fueron analizados mediante la estrategia de Monitoreo Ambulatorio, y un niño que fue internado en un hospital de Buenos Aires. Afortunadamente, todos los pacientes están transitando la enfermedad sin complicaciones.
Garantías en la Vigilancia Sanitaria
El Ministerio de Salud destacó que cada jurisdicción tiene la responsabilidad de llevar a cabo investigaciones epidemiológicas necesarias y brindar atención oportuna a los nuevos casos. Aseguró que la circulación de virus respiratorios en el país se mantiene dentro de los parámetros esperados para esta época del año.
Características del Subclado K
Gracias al análisis genómico, se estableció que los virus corresponden al subclado K, el cual presenta mutaciones que podrían aumentar la transmisibilidad del virus. Esto, según el Ministerio, podría llevar a un incremento en los casos y en la demanda de atención sanitaria.
Evaluación de la Severidad Clínica
A pesar de las características que presenta el subclado K, la evidencia actual sugiere que no hay indicios de que este virus cause una mayor severidad clínica en comparación con otros tipos de influenza A(H3N2) que han circulado en temporadas pasadas.